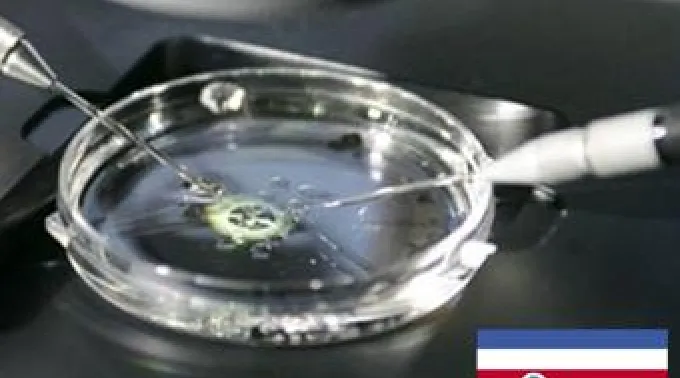
21_NOV_invitrocostarica.jpg ??

LIMA, 14 de fev de 2012 às 07:49
Sessenta e seis organizações pró-vida da América Latina lidaram para Costa Rica para não permitir que a Corte Inter Americana dos Direitos Humanos (Corte IDH), impusesse a fecundação in vitro no país porque significaria abrir a porta à despenalização do aborto em toda a região.
No seu boletim de 9 de fevereiro o Population Research Institute (PRI)se referiu à denúncia que a Comissão Interamericana de Direitos Humanos (Comissão IDH) alegou o uso contra Costa Rica "pela suposta violação dos “direitos reprodutivos” de 10 casais costarriquenses com problemas de fertilidade, devido à proibição das técnicas de reprodução assistida desde 2000, no país.
O PRI disse que esta demanda, que será vista pela Corte IDH, não deveria prosperar já que, já que nenhuma sentença ou tratado de direitos humanos reconhece a reprodução assistida como um direito humano. Logo, indicou que bastaria que Costa Rica argumentasse sobre "a falta de competência da Corte sobre esse assunto.”
No entanto, alertou sobre a atitude do Governo e dos políticos locais que não questionam a competência da Corte e “manifestaram publicamente o descaso, e escondem toda informação, ou colocam obstáculos, a qualquer um que possa intervir a favor do direito a proteção legal de toda vida humana desde a concepção".
O PRI lembrou que “os membros tanto da Comissão quanto da Corte IDH têm uma opção ideológica para interpretar os direitos humanos, no ponto de ideologia de gênero e dos chamados “direitos sexuais e reprodutivos.
Por tanto, se a Costa Rica permitir que a Corte declare a Fecundação in Vitro como "direito humano", acontecerá um precedente jurídico vinculante para todos os países membros da Convenção Americana de Direitos Humanos, debilitando assim a defesa da vida desde a concepção.
"Concluindo, toda proteção , constitucional ou legal, para a vida do concebido que reconheça ou tenha outorgado qualquer país da América Latina, corre o risco de ser revertida como um pronunciamento favorável da Corte IDH neste caso", alertou.
Entre as organizações pró-vida que ligaram para Costa Rica para defender o direito à vida e o respeito aos direitos humanos, estão a Red por la Vida y la Familia (Chile), Fundación Familia y Futuro (Ecuador), Centro de Bioética, Persona y Familia (Argentina), Fundación Vive (Colombia), Coordinadora Nacional Unidos por la Vida y la Familia, Asociación Vida y Familia, Médicos por la Vida, Alianza Latinoamericana para la Familia (Perú), Sociedad de Bioética de Honduras, Instituto Panameño de Educación Familiar, entre outros.